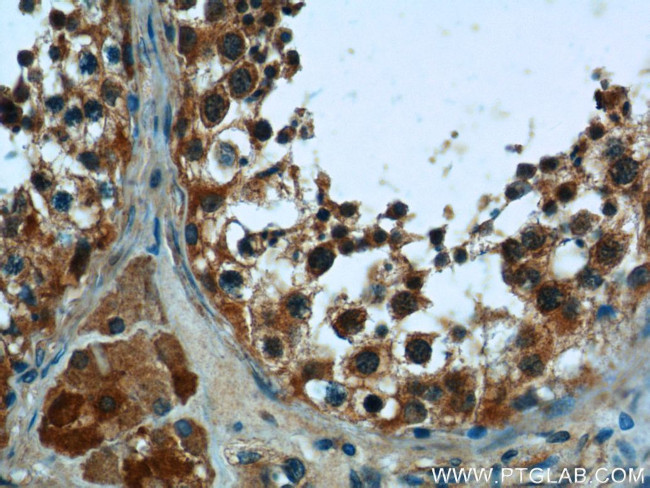
PNLDC1 Antibody in Immunohistochemistry (Paraffin) (IHC (P))
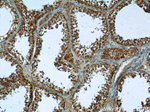
PNLDC1 Antibody in Immunohistochemistry (Paraffin) (IHC (P))

Search
Proteintech
PNLDC1 Polyclonal Antibody
{{$productOrderCtrl.translations['antibody.pdp.commerceCard.promotion.promotions']}}
{{$productOrderCtrl.translations['antibody.pdp.commerceCard.promotion.viewpromo']}}
{{$productOrderCtrl.translations['antibody.pdp.commerceCard.promotion.promocode']}}: {{promo.promoCode}} {{promo.promoTitle}} {{promo.promoDescription}}. {{$productOrderCtrl.translations['antibody.pdp.commerceCard.promotion.learnmore']}}
产品信息
25559-1-AP
种属反应
已发表种属
宿主/亚型
分类
类型
抗原
偶联物
形式
浓度
规格
纯化类型
保存液
内含物
保存条件
运输条件
产品详细信息
Immunogen sequence: EFTGLRSNL SGPQQISLFD LPSEWYLKTR QSVQQFTVCQ IGLSVFSAIE GEANKYIAHS CNFYLFPTTF GILDSEFSFQ ASSVQFLNQY GFNYNKFLKN GIPYMNEEQE KKIRHDILTG NWRVRSSPDK DQIKVVIDEV TRWLELAKEG DWMTLPGITG FQAFEVQLVL RQALPNIWTV LKDEGVVVKK VSKQHRWYLQ NTSCDRESCW KENILLSARG FSVFFQMLVK AQKPLVGHNM MMDLLHLHEK FFRPLPESYD QFKQNIHSLF PVLIDTKSVT KDIWKEMNFP RVSNLSEVYE VLNSDLNPTK NSGPEIVHAS RCEKYVETKC PHEAAYDAFL CGSVLLKVAH LLLQ (19-371 aa encoded by BC112246)
靶标信息
3'-exoribonuclease that has a preference for poly(A) tails of mRNAs, thereby efficiently degrading poly(A) tails (PubMed:27515512). Exonucleolytic degradation of the poly(A) tail is often the first step in the decay of eukaryotic mRNAs and is also used to silence certain maternal mRNAs translationally during oocyte maturation and early embryonic development (PubMed:27515512). May act as a regulator of multipotency in embryonic stem cells. [UniProt]
仅用于科研。不用于诊断过程。未经明确授权不得转售。
生物信息学
蛋白别名: HsPNLDC1; PARN like, ribonuclease domain containing 1; PARN-like domain-containing protein 1; poly(A)-specific ribonuclease (PARN)-like domain containing 1; Poly(A)-specific ribonuclease domain-containing protein 1; poly(A)-specific ribonuclease PARN-like domain-containing protein 1; Poly(A)-specific ribonuclease PNLDC1; unnamed protein product
基因别名: Gm313; HsPNLDC1; PNLDC1; SPGF57; Trimmer
UniProt ID: (Human) Q8NA58, (Mouse) B2RXZ1
Entrez Gene ID: (Human) 154197, (Mouse) 240023